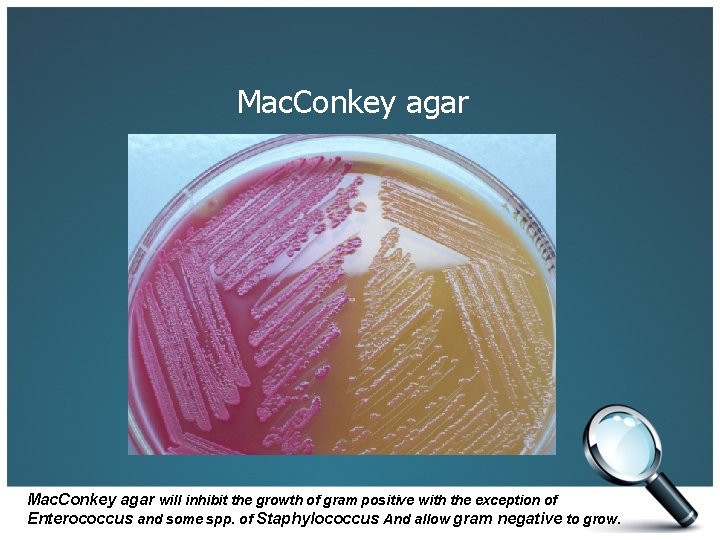
Mac. Conkey agar will inhibit the growth of gram positive with the exception of
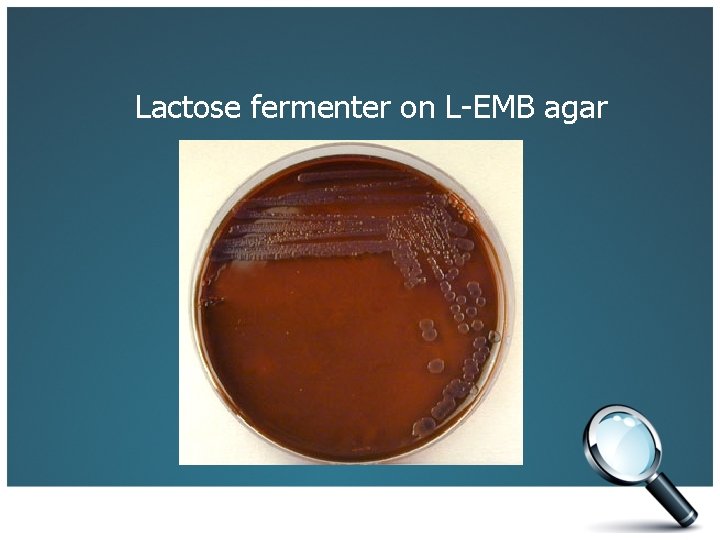
Lactose fermenter on L-EMB agar
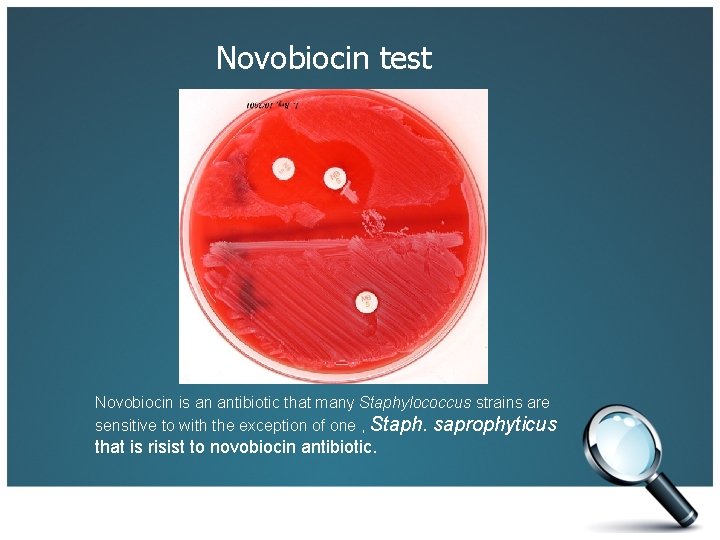
Novobiocin test Novobiocin is an antibiotic that many Staphylococcus strains are sensitive to with

GENERAL REVISION MEDICAL MICROBIOLOGY LAB MEDI 3101 GENERAL

GENERAL REVISION MEDICAL MICROBIOLOGY LAB MEDI 3101

GENERAL REVISION • • • Gram Stain. Acid Fast Stain. Endosperm Stain. Capsule Stain. Flagella Stain. Motility test. Catalase test. Oxidase test. Urease test. Coagulase test. Gelatin liquefaction test. Starch hydrolysis test. IMVi. C tests. Nitrate reduction test. Single media / Multiple tests. Selective and Differential media. Oxidation Fermentation medium.

Bacterial Staining q Differential Stains: I. Gram Stain. II. Acid Fast Stain. q Special Stains: I. Endospore Stain. II. Capsule Stain. III. Flagella Stain.

Gram Stain Gram Positive Gram Negative i. bacilli ii. cocci

Gram Positive bacilli

Gram positive cocci

Gram positive cocci

Gram positive cocci

Gram negative bacilli

Gram negative cocci

Acid Fast Stain Ziehl neelson method

Acid Fast bacilli

Endospore Stain Schaffer Fulton method

Endospore Stain Schaffer Fulton method

Capsule Stain I. Gin’s method II. Anthony’s method

Capsule Stain I. Gin’s method

Capsule Stain II. Anthony’s method

Motility test I. Semisolid media II. Flagella stain III. Hanging drop technique

Motility test I. Semisolid media

Motility test II. Flagella stain (leifson method)

Motility test II. Flagella stain (presque isle method)

Motility test III. Hanging drop technique

Biochemical tests I. Catalase test. II. Oxidase test. III. Coagulase test. IV. Gelatin liquefaction test. V. Starch hydrolysis test. VI. Urease test. VII. IMVi. C tests. VIII. Nitrate reduction test. IX. Single media / Multiple tests. X. Selective and Differential media. XI. Oxidation Fermentation medium.

Catalase test

Oxidase test

Coagulase test Negative Positive Slide method Positive Negative Tube method

Gelatin liquefaction test Nutrient Gelatin

X- Ray or Gelatin Film test The organism on the left does not hydrolyze gelatin and, therefore, no clearing of the gelatin film is seen. On the right, the portion of the strip submersed in the organism suspension has cleared, indicating gelatin hydrolysis.

Starch hydrolysis test Positive Negative

IMVi. C tests: I. III. IV. Indole production test. Methyl Red test. Voges-Proskauer test. Citrate Utilization test.

Indole production test Negative Positive

Methyl Red test Negative Positive

Voges-Proskauer test Positive Negative

Citrate Utilization test Positive Negative

Urease test Negative Positive

Nitrate reduction test

Single media / Multiple tests I. SIM medium. II. Kliger's Iron agar (KIA). III. Triple Sugar Iron agar (TSIA). IV. Lysine Iron agar (LIA). V. Motility Indole Ornithine (MIO) medium.

SIM medium

SIM medium

SIM medium


Lysine Iron agar (LIA)

Motility Indole Ornithine medium

Selective and Differential Media I. Eosin Methylene Blue agar ( EMB ). II. Mannitol Salt Agar ( MSA ). III. Mac. Conkey Agar. ( MAC ).
Mac. Conkey agar will inhibit the growth of gram positive with the exception of Enterococcus and some spp. of Staphylococcus And allow gram negative to grow.

Mannitol Salt agar Staph. epidermidis Staph. aureus

Mannitol Salt agar

Escherichia coli on L-EMB agar

Lactose non-fermenter on L-EMB agar
Lactose fermenter on L-EMB agar

Oxidation Fermentation medium A B C A. Green in both tubes indicates that the organism cannot metabolize glucose. B. Oxidative metabolism indicated by yellow in the aerobic tube and green in the anaerobic tube. C. Both tubes yellow indicate fermentation only

Blood agar Hemolysins are exotoxins produced by bacteria which cause lysis of red blood cells in vitro.

Chocolate agar
Novobiocin test Novobiocin is an antibiotic that many Staphylococcus strains are sensitive to with the exception of one , Staph. saprophyticus that is risist to novobiocin antibiotic.

Bacterial Oxygen Requirements
- Slides: 55